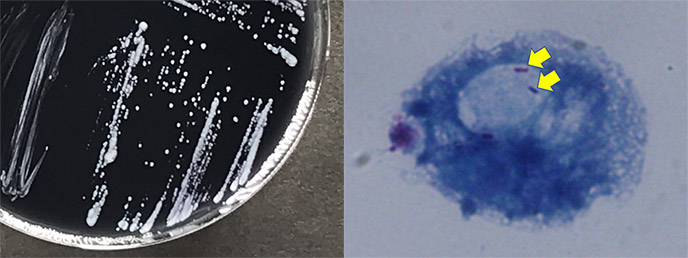

Tiiメルマガ(Vol.22)2021-10-30
「情報インフラ」の テック・アイ技術情報研究所 です。
このメルマガは、配信を希望された会員の皆様に、最新の情報をお届けします。
(今回は2021年10月15日~10月29日の新着情報です。)
Tii会員サイトの新着情報

金属部門のデータリスト(ver.20210901)
7.金属部門のデータリスト(ver.20210901)テック・アイ技術情報研究所で、2021/2/11から8/31の約半...

繊維部門のデータリスト(ver.20210901)
6.繊維部門のデータリスト(ver.20210901)テック・アイ技術情報研究所で、2021/2/11から8/31の約半...
プレミアム会員サイトの新着情報

金属部門のデータリスト(ver.20210901)
7.金属部門のデータリスト(ver.20210901)テック・アイ技術情報研究所で、2021/2/11から8/31の約半...

繊維部門のデータリスト(ver.20210901)
6.繊維部門のデータリスト(ver.20210901)テック・アイ技術情報研究所で、2021/2/11から8/31の約半...
Tii技術情報の新着情報

未来の廃プラケミカルリサイクリングのガイドライン (Research guides future of plastic waste chemical recycling )
廃棄プラスチックのケミカル・リサイクルに関する帰結的ライフサイクル最適化(CLCO)のフレームワークを発表。CLCO は...

リチウムの供給量と効率性を向上させる水からリチウムを引き出す技術
汚染水からリチウムを選択的に抽出するメンブレン技術を開発。かん水からのリチウム抽出プロセスを簡易化し、リチウムの供給量の...

MOF で光を放つペロブスカイト LEDs (Perovskite LEDs shine in metal-organic framework)
金属有機構造体(MOF)の薄膜で安定化したペロブスカイトナノ結晶による発光ダイオード(LED)の優れた性能を実証。MOF...

電気で起こす化学反応 (Electrically driven chemistry)
鉄ベースの金属有機構造体(MOF)を室温下で電気合成する、スケーラブルでサステナブルな新技術を開発。

分子の糊で作るナノサイズの「カメラ」が化学反応のリアルタイムモニタリングを可能に
リアルタイムで化学反応をモニタリングするナノスケールのカメラのように機能する、微細な半導体ナノ結晶デバイスの作製技術を開...

リチウムイオン電池の寿命を非破壊で延長できる容量回復技術を開発
リチウムイオン電池(LIB)の寿命を非破壊で延長できる容量回復技術を開発しました。LIB内で失活して充放電に寄与しないリ...
街路の歩行者空間化は小売店・飲食店の売り上げを上げるのか、下げるのか?
歩行者空間の分布を広範囲で収集する手法を開発し、その経済的な影響を検証しました。スペイン全域のオープンストリートマップ(...

土砂災害が発生する危険性の高い雨の降り方を判定する
土砂災害が発生する危険性が高い豪雨の特徴を明らかにしました。平均雨量が100年に一度の確率の値に達した際に、土砂災害が発...

プラスチックを肥料に変換するリサイクルシステムを開発
植物を原料としたプラスチックをアンモニア水で分解し、肥料となる尿素に変換するリサイクルシステムを開発。リサイクルシステム...

東京ドームで「声を出さない応援」を測定、分析する実証実験を実施
東京ドームで開催されたプロ野球 読売ジャイアンツ戦で、会場全体の音から歓声音のみを抽出・分析する実証実験を実施し、歓声の...

「富岳」を用いた宇宙ニュートリノの数値シミュレーションに成功
2021年ゴードン・ベル賞ファイナリストに選出2021-10-28 筑波大学本研究では、ブラソフシミュレーションと呼ばれ...

フジドリームエアラインズ エンブラエル式ERJ170-200STD型機[滑走路からの逸脱](山形空港、平成31年4月23日発生)
フジドリームエアラインズエンブラエル式ERJ170-200STD型JA11FJは、機長ほか64名が搭乗し、山形空港から県...

個人ランズ式S-7クーリエ-R503L型機(超軽量動力機、複座)の事故[樹木の中へ墜落](茨城県守谷市、令和3年2月20日発生)
個人所属ランズ式S-7クーリエ-R503L型(超軽量動力機、複座)JR1734は、茨城県守谷市大柏の離着陸場の場周経路を...

ANAウイングス ボーイング式737-800型機の事故[機体の動揺による客室乗務員の負傷](愛媛県大洲市の上空、令和2年4月12日発生)
ANAウイングスボーイング式737-800型JA64ANは、令和2年4月12日(日)、運送の共同引受による全日空の定期4...

界面の高品質化と平坦性向上によりSiC半導体の性能を6~80倍向上
SiC(シリコンカーバイド)半導体で問題になっていた欠陥(不完全性)を独自の手法で大幅に低減し、実用的な構造でSiCトラ...

自然環境の干ばつを再現した自動潅水かんすい制御システムを開発
ポット底面からの給水により1ポットごとに土壌水分を任意に制御する世界初の自動潅水システムを開発しました。本システムでは自...

機械学習による世界最速の3次元電子顕微鏡ナノイメージング
機械学習を活用したノイズフィルターを組み込んだ新しい電子顕微鏡の計測手法を開発し、物体の内部をナノメートル(100万分の...

すばる望遠鏡、塵のベールに包まれた原始銀河団の謎を解く
すばる望遠鏡などを用いた観測によって、プランク衛星で見つかった非常に明るいサブミリ波源 (PHzG237.01+42.5...

H-IIAロケット44号機による準天頂衛星初号機後継機の打上げ結果について
種子島宇宙センターから2021年10月26日11時19分37秒(日本標準時)に、準天頂衛星初号機後継機を搭載したH-II...

森林を守ることが海の生物多様性を守ることにつながる
日本全国22河川を対象とし、環境要因・社会要因・土地利用要因などのビッグデータと環境DNA分析による沿岸魚類群集データと...

グラファイトを用いた3次元的な熱流制御により超高性能ヒートスプレッダを実現
パワー半導体の高い放熱性能の実現に向けて、異なる配向のグラファイト材を重ねて接合したヒートスプレッダを開発し、グラファイ...

コバルトを廃石から回収する技術、豪と共同研究へ
クイーンズランド州の銅鉱山の廃石からコバルトを回収する技術についての共同研究実施に合意しました。豪クイーンズランド州他で...

札幌の積雪中に存在する光吸収性粒子が融雪に与える影響を国内・国外由来に分離して推定しました
雪面が吸収する太陽光を増加させ、融雪を加速する可能性があります。積雪変質モデルと領域気象化学モデルを組み合わせて、201...

巨大な海洋渦が暖かい海水を南極大陸方向へ運ぶ東南極トッテン氷河を下から融かす主要な熱源
東南極で最大級の規模を有するトッテン氷河の周辺域では、近年、氷床質量の減少が報告され、また、将来の大規模な氷床流出も懸念...

令和3年10月20日11時43分の阿蘇山噴火に伴う地殻変動
10月20日11時43分に発生した阿蘇山の中岳第一火口での噴火に伴う顕著な地殻変動は、検出されていません。令和3年(20...

最少の実験回数で高い予測精度を与える汎用的AI技術を開発
化学マテリアルズオープンプラットフォームからなる水平連携において、強度や脆さといった材料物性を機械学習で予測する際に、材...

すばる望遠鏡、生まれたての太陽系外惑星を発見
すばる望遠鏡等を用いた直接撮像観測により、若いM型矮星に付随する、年齢 200 〜 500 万年ほどの惑星「2M0437...

リンが欠乏した植物の成長に必要な化合物を発見~痩せた土地における農業技術への応用に期待~
「ホスホコリン」という化合物がリン欠乏状態の植物の成長に必要であることを発見しました。養分の少ない土壌における農作物の増...

東京ドーム 巨人戦で日本初「8K カメラ×AI 自動編集×マルチアングル映像体験」の技術実証を実施
東京ドーム内に複数台設置した 8K カメラを活用し、自動で撮影した映像を AI が即時に編集することで、シーンに応じて選...

ドコモと UR 都市機構が団地におけるスマート技術活用の取り組みを推進
横浜市・金沢シーサイドタウン並木一丁目第二団地において、UR 賃貸住宅にお住まいの方々をモニターとして自動配送・遠隔操作...

組合せ最適化処理に適したCMOSアニーリングを高速の金融商品取引に適用するための技術を開発
組合せ最適化問題の処理に適したCMOSアニーリングを、高速の金融商品取引に適用するための技術を開発しました。平均回帰性を...

世界で初めて光集積回路化により小型化した量子暗号通信システムの開発・実証に成功
量子暗号通信システムの主要構成機能である、量子暗号鍵の「送信」、「受信」とそのための「乱数発生」について、従来の光学部品...

ポリマー半導体の高性能化に向けた新たな分子デザイン手法を開発
ポリマー半導体の化学構造を少し組み替えるだけで、電荷となるπ電子が主鎖に沿って高度に非局在化し、半導体性能の一つである電...

マイクロ波と光のアンサンブル ~マイクロ波・光協働化学とカーボンニュートラルへ期待~
光とマイクロ波の協働的な触媒的化学合成反応系の開発に成功しました。有機分子であるフェニルアセチレンを光触媒とするジメチル...

鉄系高温超伝導体で世界最高の超伝導電流を実現 ~強磁場発生用磁石応用へ前進~
鉄系高温超伝導体のうち、最も実用化が期待されている物質である(Ba,K)Fe2As2で、数テスラという比較的大きな磁場中...

雪の下で作物を腐らせる「雪腐病ゆきぐされびょう」の謎に迫る。実験植物を使って雪腐病菌への強さを調べられる実験系を開発
雪腐病は、麦類や牧草を枯らす重要病害です。実験植物であるシロイヌナズナに感染する雪腐病菌を初めて特定し、シロイヌナズナを...

家族形態の起源と社会構造の多様性。進化シミュレーションが解き明かす環境要因、家族形態、社会構造の関係
計算機上に農村社会のモデルを構築し、環境条件に応じて多様な家族形態が生起すること、そして家族形態に応じて社会内の所得分布...

電子が動くことのできない磁性絶縁体における マグノンの表面状態と新規輸送現象を理論的に解明
マグノンの波動関数の非自明なトポロジーに由来して、質量をもたないディラック粒子のような分散を持つマグノンが表面に現れる磁...

環境低負荷な精密高分子合成に成功~無溶媒で進行する自己触媒的な超分子重合~
「フタロニトリル」分子を原料とし、「フタロシアニン」の超分子ポリマーを無溶媒という環境負荷の少ない条件下で合成することに...

福徳岡ノ場で確認された新島の大きさについて(令和3年10月20日時点)
8月13日からの福徳岡ノ場での火山活動により新島が生じたことが確認されています。米国航空宇宙局(NASA)/米国地質調査...

Arm® Cortex®-M4搭載マイコン「TXZ+TMファミリー アドバンスクラス」の新製品量産開始について
40nmプロセスを採用したArm® Cortex®-M4搭載(FPU機能付き)、新32ビットマイコン製品群「TXZ+ T...

世界初の洋上用CO2回収装置検証プロジェクトで排ガスからのCO2分離・回収に成功
洋上用CO2回収装置の検証プロジェクト“CC-Ocean(Carbon Capture on the Ocean pro...

8月の収穫直後から甘い サツマイモ新品種「あまはづき」~ ねっとり甘い焼き芋を、ひと足はやく食卓に~
8月頃からねっとり甘い焼き芋をつくれるサツマイモ新品種「あまはづき」を開発しました。「あまはづき」は、糖度がきわめて高く...

X線バースト天体における不安定マグネシウム燃焼の解明
国際共同研究グループは、これまでの研究で十分に理解されていなかった、X線バースト天体における不安定核マグネシウムの重要な...

ドローンが海中・海底探査の母船に?
無人航空機(UAV)を自律型無人潜水機(AUV)などの自律的な海中・海底観測機器の母船として運用することで、高効率・高機...

優れた室温成形性と強度、高い熱伝導率を有する「ZA系新マグネシウム合金圧延材」を新開発
優れた室温成形性と強度、高い熱伝導率を有する「ZA系新マグネシウム合金圧延材」を新開発した。

信頼性が高いガスタービンのシステム設計を自動で効率良く発見する技術を開発
ガスタービンの制御システム設計で与えられた複数の要求仕様を満たす設計を自動で発見する手法を開発しました。従来の手法を改良...

星形成領域は大型有機分子の宝庫
アルマ望遠鏡で取得された「いて座B2」の観測データから、これまでに宇宙から検出されたペプチドに似た分子としては最大のもの...

「アルマ望遠鏡、観測開始から10年」
アルマ望遠鏡は直径12メートルのパラボラアンテナ54台、直径7メートルのパラボラアンテナ12台の計66台を結合させ、全体...

脱水を伴う新しい還元反応の発見~電気化学反応と脱水反応を組み合わせた新しい機能性材料の開拓~
脱水反応を、電気化学反応と組み合わせることで、コバルト酸化物中の酸素を大量に取り除き、チューブ型の構造をえることに成功し...

有機無機ペロブスカイトの光誘起構造変化を観測~次世代太陽電池の性能向上に期待~
複数種のハロゲン化物イオンを含むペロブスカイトを対象に、光照射による発光特性の変化がサブオングストローム(Å)レベルのご...

特殊路面6種類を新設したテストコースでの実験を開始
運転時の生体の情報や状態を推定する研究を実施している。研究のさらなる進展を図るため、今回新たな特殊路面を設けたテストコー...

人工知能により材料の構造画像を生成し、物性を予測する技術を開発
人工知能(AI)によって材料の構造画像を生成し、物性予測を可能とする技術を開発した。カーボンナノチューブ(CNT)を用い...

スペクトルから思いもかけない物性をAIが予測
人工知能技術を利用することで1つのスペクトルから多数の物性情報を得ることに成功しました。「内殻電子励起スペクトル」の解析...

黒潮とメキシコ湾流の同期現象を発見~大気と海洋の相互影響によってもたらされる異常気象の解明に道~
北半球最強の暖流である黒潮とメキシコ湾流は、大陸を隔てて約一万キロメートルも離れています。それにもかかわらず、二つの海流...

ホロー原子を使ったX線レーザーの短パルス化~X線の時間幅を制御する非線形光学素子を実現~
内殻電子を失った原子(ホロー原子)を利用した「非線形光学効果」によって、X線自由電子レーザー(XFEL)施設「SACLA...

キログラム原器が重要文化財に~日本の質量の基準として、明治以降の近代化と産業発展に大きく貢献~
産業技術総合研究所(産総研)が所有するキログラム原器および関連する原器類を、重要文化財「メートル条約並度量衡法関係原器」...

阿蘇山の地殻変動(2021年10月26日発表)
2021年10月13日に噴火警戒レベルが2(火口周辺規制)に引き上げられた阿蘇山について、10月15日に観測された「だい...

“マッデン・ジュリアン振動” の「引き金」を特定
熱帯域で巨大な積乱雲群として観測されるマッデン・ジュリアン振動 (MJO) が熱帯インド洋でどのように発生するかを解析な...

直接光子による陽子内グルーオンの運動の観測に成功~グルーオンの回転運動はあまり大きくなかった~
米国ブルックヘブン国立研究所(BNL)のRHIC衝突型加速器を使い、偏極陽子と陽子の衝突から生じる直接光子の「横スピン非...

世界最高品質の単元素トポロジカル・ディラック半金属を実現
世界最高品質のα-スズ(α-Sn)薄膜をIII-V族半導体インジウムアンチモン(InSb)基板(001)上に結晶成長(エ...

岩石惑星の形成過程を左右する中心星の元素組成
すばる望遠鏡を含む大型望遠鏡を用いた観測により岩石惑星をもつ星の元素組成を精密に測定し、中心星の組成と岩石惑星の組成に相...

天文学者が大きな望遠鏡をつくろうとするわけ
2021-10-15 国立天文台超大型望遠鏡TMTの完成予想図。(クレジット:国立天文台)10月2日は「望遠鏡の日」とも...
Tii建設技術の新着情報
むつ市(青森県)の中心市街地における「居心地が良く歩きたくなる」まちなかづくりを支援!
民都機構は「まちなか公共空間等活用支援事業」の第1号案件として、むつ市から都市再生推進法人として指定を受けている田名部ま...

2021年8月11~19日の佐賀県東部の土砂災害における衛星画像からの斜面変動範囲の推定
2021年8月豪雨で災害のあった佐賀県東部を対象に、災害前後の衛星画像から作成したNDVI(正規化植生指数)差分画像を用...

グリーンスローモビリティを活用し、東京都港区の交通課題の解決を目指した実証実験を実施
国土交通省の公募に対して、「都心区における旅行者・居住者向けマイクロツーリズムの実証実験」を事業主体である東京都港区と連...

土工用リサイクル材料「ナスファインサンド」(KT-210063-A)
ステンレス原料を製錬する際に発生するスラグを微粒状に粒度調整して盛土、埋戻し等に使用するリサイクル材料。

防風・防砂・防雪用樹脂ネット「WSSレノシート」(KT-210064-A)
ポリエステル製織物(絡み織)にアクリルコーティングを施した防風・防砂・防雪用の高強度繊維シートで、4mスパンによる基礎数...

ボンドVMクリア工法(KT-210065-A)
強靭で耐候性に優れる透明なウレアウレタン樹脂を用いたコンクリート片剥落防止工法で、下地の視認、工期短縮が可能となる。

ワンダーフレックス(KK-210042-A)
橋梁用伸縮継手装置設置工において、大遊間700mmまで対応可能となった橋梁用ゴム製伸縮装置の製品技術である。

燃料電池を用いた夜間照明(KK-210043-A)
夜間工事等において使用する照明器具の電源(発電装置)を燃料電池式とした製品技術である。

循環式2ノズルバキュームブラスト工法(KK-210044-A)
ブラスト工法において、研削材を回収でき、2ノズルで2人同時施工が可能な工法技術である。

LEDユニット交換式道路照明器具(KK-210045-A)
光源・電源装置などをユニット構造とし、更新時に照明器具本体を流用可能とした製品技術であり、ランニングコスト削減によるトー...

ルーフキャッチャー(KT-210066-A)
折板屋根に設置できる足場倒壊防止装置で、強固に足場を支持することができるため、安全性の向上が図れる。

ラバー土のう(CB-210008-A)
ラバー製(リサイクルゴム使用)特殊形状の連結式簡易防水壁の技術で、突然のゲリラ豪雨でも迅速かつ安定した施工が可能になり、...

鉄軌道の運転事故件数 過去30 年間で最小 ~鉄軌道輸送の安全に関わる情報(令和2年度)を公表~
国土交通省では、鉄道事業法第19条の3の規定に基づき、鉄道運転事故等の報告、輸送の安全に関する行政指導の実施状況、安全に...

低騒音ブレード(KT-210059-A)
スリットデザインを工夫して風切音を抑えた低騒音のコンクリートカッターブレードで、空転時の特有の風切音を低減することが可能...

ラバトップジョイント250MJ(CG-210015-A)
橋梁用埋設型伸縮継手設置において、遊間中心と特殊合材の中心位置をずらすこと、及び高伸縮性の特殊合材使用によりジョイント幅...

原位置微生物活性化型のバイオレメディエーション(EDC工法)(KT-210060-A)
微生物栄養剤(EDC)を用いて汚染土壌を原位置浄化する工法であり、本技術の嫌気性菌を活用した浸透液の注入処理により、飛散...

ロックボルト自動施工装置「ロボルト」(KT-210061-A)
ロックボルト工の削孔・モルタル充填・ロックボルト挿入設置を全自動で行うドリルジャンボで、作業員の労力削減と施工時間の低減...

フルオートドリルジャンボ(KT-210062-A)
トンネル切羽掘削における削孔工程を全自動で施工するコンピューター制御のドリルジャンボで、従来は3ブームノーマルドリルジャ...

耐震耐風目隠し通風フェンス(カクスルー)(CG-210016-A)
カクスルーは、耐震二次設計と耐風設計を施し、JIS準拠荷重試験と衝撃試験に合格した頑丈なアルミフェンスです。両側面凹と凸...

中部国際空港連絡道路での逆走を防ぐため「逆走車・誤侵入歩行者防止システム」が道路管理業務に採用
一般道から有料道路の料金所出口への逆走車両や歩行者の侵入を防ぐため,三次元レーザレーダを用いた「逆走車・誤侵入歩行者防止...

熊本地震で被災した建築物の詳細分析結果を公表します
「熊本地震で被災した鉄筋コンクリート造建築物を対象とした地震後継続使用確保に資する検討」をとりまとめました。杭の被害によ...

自然災害伝承碑
地理院地図で公開している自然災害伝承碑情報については、2020年8月21日より 自然災害伝承碑データの提供について から...
Tii生命科学の新着情報

創始者社会性仮説は、動物が新しいニッチに進出する際の長期的な社会変化を説明する
動物集団から分かれた少数個体が未開拓の生息地に進出することによって社会性に大きな変化がみられ、そのことが社会行動の進化に...

遺伝性血液疾患の原因タンパク質を制御する新規のユビキチン経路を解明~ファンコニ貧血にかかわる新たな関連因子群の同定~
ファンコニ貧血の原因遺伝子SLX4が正常に機能するために不可欠のタンパク質RNF168を新たに同定しました。

成人T細胞白血病リンパ腫(ATL)のゲノム異常の全体像を解明~がん研究における全ゲノム解析の可能性を示す~
難治性血液がんである成人T細胞白血病リンパ腫(ATL)に対して、150例の臨床検体を用いた大規模な全ゲノム解析を実施し、...

VATER症候群に類似する新規モデルマウスの作製に成功~VATER症候群の病態・発症メカニズムの解明に期待~
Dyrk2遺伝子を欠損させたマウスを新たに作製して解析を進めたところ、国の指定難病であるVATER症候群と類似した病態を...

新しい成人急性リンパ性白血病の分子分類~成人に好発する予後不良病型と日本人最大病型の発見~
日本人のAYA・成人急性リンパ性白血病としては最大規模354症例のゲノム解析を実施し、遺伝子発現データと遺伝子変異データ...

他者の予想外の行動に反応するニューロンを発見~他者行動をモニタリングする際の情報処理をする脳領野が明らかに~
サルの上側頭溝中間部に、他者の行動に反応するニューロンや、他者が予想外の行動をした時に応答するニューロンが多く存在するこ...

重層社会における群れを超えた休息行動の同期~ドローンを用いた野生ウマ集団の行動分析~
野生化したウマで休息行動の同期が群れを超えて起きることを明らかにしました。ウマにおける重層社会における群れ間の行動調整の...

キク属モデル系統の高精度全ゲノム塩基配列を決定~栽培ギク品種育成におけるゲノム情報の活用へ~
栽培ギク(六倍体)によく似た性質を持つ日本原産の二倍体種・キクタニギクの純系化系統(Gojo-0)の高精度全ゲノム塩基配...

国際共同研究による食道がん全ゲノム解析 日本人食道がんに特徴的な発がんメカニズムを発見
Cancer Grand Challenge “Mutographs project”に参加し、発症頻度の異なる8か国(...

上下動撹拌培養装置を用いた流体制御により誘導した反転型脳オルガノイド
上下動撹拌型の培養装置を用いて、非定常的に3D浮遊培養を行いながら流体制御することによって、従来の化合物を使用せずに脳オ...

MESP1とMESP2の量が中胚葉形成を決める
CRISPR/Cas9ゲノム編集技術を用いMesp1/2遺伝子変異マウスを作製・解析したところ、中胚葉細胞においてMES...

5G とスマートグラスによるマウスピース矯正歯科治療の遠隔診療支援の実証を実施
5G などを活用し、スマートグラスを用いた遠隔マウスピース矯正歯科治療支援の実証実験を行いました。5G などのドコモの携...

脳が萎縮しても認知機能が保たれる人は? ~1799人の脳ドックと脳の健康指標BHQ~
脳MRIドック受診者1799人を対象に研究を行い、脳の灰白質容積から算出したGM-BHQが、海馬の容積計測と比較して、認...

新型コロナウイルス感染症感染拡大下における 発達障害児の生活の質低下に関連する精神状態を特定
新型コロナウイルス感染症の流行拡大下において、発達障害がある子どもの生活の質(QOL)について検討し、特に睡眠スケジュー...

犬の膀胱癌の治療標的を発見!!~新たな免疫療法の臨床試験を開始~
腫瘍免疫療法の新しい標的IDO(インドールアミン2,3ジオキシゲナーゼ)1と呼ばれる分子が、種々の犬の固形腫瘍組織におい...

非アルコール性脂肪性肝疾患悪化に歯周病原細菌による腸内環境への悪影響が関係する
歯周病が非アルコール性脂肪性肝疾患(NAFLD)を悪化させるメカニズムとして、飲み込まれた歯周病原細菌による腸内環境の変...

肝臓由来の細胞外小胞の抗炎症機能を発見 ~急性肝障害の治療法に新たな道~
ヒト幹細胞由来の細胞外小胞が急性肝障害に対して組織保護的に働くことを発見しました。

ヒトiPS細胞を用いた配偶子の作製と利用をめぐる日本の一般市民を対象にした調査
ヒトiPS細胞を用いた配偶子作製やその利用について一般市民を対象に実施した調査結果に関する論文2報を発表しました。

花の数が100以上あるウワミズザクラを発見~研究素材や花⽊としての利⽤に期待~
ウワミズザクラの新品種を発⾒し、フサザキウワミズザクラと命名しました。フサザキウワミズザクラは⻑野県⻑野市の⾃然林から発...

予防的に発がんを抑制する上皮細胞による前がん細胞の認識機構を解明
非免疫細胞である上皮細胞が、がんの元となる前がん細胞を認識し、攻撃・排除するという免疫細胞様の監視システムがあることを明...

ショウジョウバエが持つユニークな性染色体を用いて性染色体進化に関する共通のメカニズムを発見
ネオ性染色体というユニークな性染色体を独立に獲得したショウジョウバエ3種を用いて、誕生した直後の性染色体がどのように進化...

メタゲノムからウイルスゲノムを洗い出せ! ~細胞の免疫記憶を使ったウイルスゲノムの網羅的検出~
原核生物の「免疫記憶(CRISPR)」を利用してメタゲノムデータからウイルスのゲノム情報を検出する方法を開発しました。既...

リンが欠乏した植物の成長に必要な化合物を発見~痩せた土地における農業技術への応用に期待~
「ホスホコリン」という化合物がリン欠乏状態の植物の成長に必要であることを発見しました。養分の少ない土壌における農作物の増...

7種のアミノ酸が脳を守り、認知症の進行を抑えることを発見!
タンパク質の構成要素であるアミノ酸のうち、7種必須アミノ酸の摂取が脳機能維持・改善をする仕組みを明らかにしました。

くるくる泳ぐ微生物 螺旋軌跡の3Dイメージング ~マイクロロボットの設計に向けて~
独自に開発をしてきた三次元位置検出光学顕微技術を用いて、繊毛虫テトラヒメナが右手系の回転をしながら右螺旋を描くように遊泳...

TMPRSS2とカテプシンBを標的とした新型コロナウイルスの感染阻害
新型コロナウイルス(SARS-CoV-2) 感染においてTMPRSS2とカテプシンBが重要な役割を担うことを見出しました...

コロナ禍の子どもの心の実態調査 摂食障害の「神経性やせ症」が1.6倍に
国立成育医療研究センターが行っている子どもの心の診療ネットワーク事業では、新型コロナウイルス感染症流行下の子どもの心の実...

脳内で生合成されるトランスフェリンはアルツハイマー病の新規バイオマーカーとなる
脳脊髄液中にアルツハイマー病の新規糖鎖マーカーを見出しました。

手と足の感覚は、実は脳の中でつながっていた。脳障害による活動変化の広がりを見ることで常識を覆す発見、脳機能・疾患機序の理解へ前進
化学遺伝学法という脳活動の操作法と、全脳の活動が見える機能的磁気共鳴画像法(fMRI)を組み合わせて、一部の脳活動をピン...
南極の湖から新種のレジオネラ属菌の単離培養に成功 本属としては初の低温耐性菌
第60次南極地域観測隊(2018年~2019年)が採取した南極の湖の堆積物からレジオネラ属菌を探索し、その培養に成功しま...

泳ぐ微生物が海まで流されない理由 ~SDGsに欠かせない小さな生物たちの振る舞いを解明~
単細胞の繊毛虫テトラヒメナが水中の構造物付近で走流性を示す機構を明らかにしました。流れ場でのテトラヒメナの動きを顕微鏡観...

勝ちばかりでも、負けばかりでも、「無謀な賭け」につながる
事前のギャンブルで勝った経験が多いと「無謀な賭け」 (負けが見込まれる局面における多額の賭け) を行いやすいという現象の...

未熟な行動出力の感覚フィードバックを介した運動回路の自己構築
遺伝子操作によりショウジョウバエの体性感覚を担う神経細胞の機能を特異的に阻害することで、運動経験の感覚フィードバックが運...

大腸がんが免疫の攻撃から逃れる機序を解明
免疫チェックポイント阻害剤が有効とされるマイクロサテライト不安定性大腸がんにおいて、免疫細胞が、がん細胞を認識して攻撃す...

希少がんの治療開発をアジア・太平洋地域5か国と連携し推進 「MASTER KEY Asia」開始
患者数が少なく、治療開発が困難とされる、希少がんを対象に、マレーシア、タイ、インドネシア、フィリピン、ベトナムのアジア5...

ウレアプラズマによる宿主細胞死の回避~気配を消す流早産原因菌の戦略~
流早産の原因として重要な細菌であるウレアプラズマが、感染した胎児や子宮の細胞の中で栄養を受け続けるために感染細胞を殺さな...

疲弊したT細胞を若返らせ、強い抗腫瘍効果をもつT細胞の作製に成功
疲弊したT細胞を若返らせ強い抗腫瘍効果を持つT細胞へと転換する簡便な方法を開発することで、より効果的なCAR-T療法を実...

栽培化歴のある雑草ヤハズエンドウのゲノム多様性
全国12地点から採取した1243個体のヤハズエンドウ(別名カラスノエンドウ)のゲノムを比較し、その遺伝的多様性を評価しま...

精子幹細胞は、未分化状態と分化状態の間を転移しながら精子を作り続ける
マウス精子幹細胞の目印となる遺伝子を発見し、新しい性質を明らかにしました。それらの遺伝子をもとに観察すると、①精子幹細胞...

愛知県がんセンターと富士通、がん患者ごとの遺伝子変異に基づき治療薬の選択をAIにより支援するシステムを開発
がん患者のがん種や多様な遺伝子変異に基づき、様々な治療薬から、効果が期待される薬剤をAIにより効率よく絞り込むことができ...

体内で放射線がん治療を行う「アルファ線内用療法」に必要な材料、アクチニウム225の高効率・高品質な製造技術を世界で初めて確立
放射線がん治療法の一つであるアルファ線内用療法に必要な、アクチニウム225(以下、アクチニウム)を、高効率・高品質に製造...

急性白血病治療における臍帯血移植後の合併症が及ぼす予後への影響
日欧における臍帯血移植後のGVHDが予後に及ぼす影響を明らかとしました。GVHDが予後に及ぼす影響が日欧で異なること、日...

炎症が制御される新たなメカニズムの解明
炎症を抑えるブレーキとしての働きをもつRegnase-1(レグネース-1)が、感染などによって炎症を起こす刺激下では「1...

電解水透析で重度の透析関連疲労感をほぼ消失~透析患者の社会復帰への貢献に期待!~
慢性維持透析患者に電解水透析を行ったところ、透析翌日まで疲労感の継続している重度疲労の患者の主観的疲労感が8週間経過時に...

乳がん発症の超早期に微小環境を作り出す仕組みを分子レベルで発見
乳がん発症の超早期に、間質細胞、免疫細胞などが集まる微小環境(がん細胞を取り囲むいわゆるニッチと呼ばれる場)が作り出され...

効率よい抗体反応の形成に必要なTリンパ球因子の発見
ヒト検体およびマウスモデルを用いた研究で、転写因子Tox2がTFH細胞の持続、メモリーTFH細胞への分化に重要であること...

RNAウイルスの増殖を抑え込む、2段階目の防御戦略を発見~DNAウイルスへの反応経路を利用~
マイナス一本鎖RNAウイルス(モノネガウイルス)目に属する麻疹ウイルスが感染した細胞内で、RNAセンサーだけではなく、こ...

モノクローナル抗体のつくる責任、つかう責任を定量化
モノクローナル抗体製造における培養工程からの環境影響を、ライフサイクルアセスメント(LCA)を用いて評価し、抗体治療によ...
このメールは、会員プランにご登録いただいた方に、毎月2回(15日、30日)送信しております。
このメール宛にご返信いただいてもお答えすることができません。ご了承ください。
お問い合わせはこちらまで:info@tiisys.com
[配信停止]
メールの受信をご希望されない場合は、こちらよりお手続きお願い致します。
©2017 テック・アイ技術情報研究所
このメール宛にご返信いただいてもお答えすることができません。ご了承ください。
お問い合わせはこちらまで:info@tiisys.com
[配信停止]
メールの受信をご希望されない場合は、こちらよりお手続きお願い致します。
©2017 テック・アイ技術情報研究所


